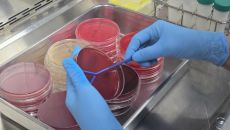

언론사별 뉴스
2025
일
월
화
수
목
금
토
-

박명숙 경기도의원, ‘달달버스’와 함께 양근대교·양동 일반산업단지 현장 점검
경기도의회 건설교통위원회 박명숙 의원(국민의힘, 양평1)은 4일 김동연 경기도지사의 민생현장 투어 ‘달달버스’ 일정에 동행해- 4시간전
- 서울신문
-

여의도에서 ‘지구당 부활’ 외친 남인순…4선 중진의 기득권 내려놓기 왜 [주간 여의도 Who?]
매주 금요일 [주간 여의도 Who?]가 온라인을 통해 독자를 찾아갑니다. 서울신문 정당팀이 ‘주간 여의도 인물’을 선정해 탐구- 4시간전
- 서울신문
-

유호준 경기도의원, 선감학원 국가폭력, 경기도는 가해자로서 기록진실치유 책임져야
경기도의회 유호준 의원(더불어민주당·남양주 다산·양정)이 12월 4일 열린 「선감학원 아동인권침해 사건 치유와 회복을 위한 토- 4시간전
- 서울신문
-

세계도핑방지기구 총회 폐막...도핑근절 ‘부산선언’ 채택
세계도핑방지기구(WADA) 부산 총회가 5일간의 일정을 마치고 5일 폐막했다. 1일부터 부산 벡스코에서 열린 WADA 총회는- 4시간전
- 서울신문
-

민주, 대의원·당원 ‘1인 1표제’ 중앙위서 부결
정청래 더불어민주당 대표의 전당대회 공약인 대의원·권리당원 ‘1인 1표제’ 관련 당헌 개정안이 5일 당 중앙위원회에서 부결됐다- 4시간전
- 서울신문
-
전남동물위생시험소, 고품질 원유 생산 총력
전라남도동물위생시험소가 고품질 원유 생산을 위해 낙농가 원유 공영화 검사와 젖소 유방염 관리 체계 강화에 나섰다. 동물위생시험- 4시간전
- 서울신문
-

쏠(Ssol)필하모닉 오케스트라, 19일 제3회 정기연주회 개최… “크리스마스의 감동 선사”
클래식 음악의 대중화를 지향하는 쏠(Ssol)필하모닉 오케스트라(이하 쏠 필하모닉)가 오는 12월 19일 목요일 저녁, 고양- 4시간전
- 서울신문
-

“오직 승리, 아무 느낌 없어”…저무는 르브론의 시대, 19년·1297경기 두 자리 득점 행진 끝
미국프로농구(NBA)를 대표하는 르브론 제임스(로스앤젤레스 레이커스)의 시대가 점차 저물고 있다. 19년 동안 이어온 두 자릿- 5시간전
- 서울신문
-

한은 “국내 AI 인력 임금 프리미엄 6%… 美 4분의 1 수준”
국내 인공지능(AI) 전문 인력이 5만 7000명대로 확대됐지만 임금 보상은 여전히 주요국에 크게 못 미치고 해외 유출은 지속- 5시간전
- 서울신문
-

신동원 서울시의회 보건복지위원회 부위원장, ‘2025 복지공동체 성과 공유회’ 참석
서울시의회 보건복지위원회 신동원 부위원장(국민의힘, 노원1)은 지난 4일 서울시청 본관 8층 다목적홀에서 열린 ‘2025년 복- 5시간전
- 서울신문
-

대통령실, ARM과 시스템반도체 인재 육성…‘ARM 스쿨’ 추진
정부와 소프트뱅크의 자회사이자 글로벌 팹리스(반도체 설계) 기업인 ARM(이하 암)이 5일 반도체 설계 인력 양성을 위한 양해- 5시간전
- 서울신문
-

전남도, 정책자문위원회와 미래 전략 재정비
전라남도는 5일 도청 왕인실에서 2025년 정책자문위원회 회의를 열어 도정 성과와 새 정부 국정과제에 반영된 전남의 주요 정책- 5시간전
- 서울신문
-

중국, 결국 선 넘을까…“군경 함정 100여척 배치, 역대급 무력시위” [핫이슈]
[서울신문 나우뉴스] 다카이치 사나에 일본 총리의 대만 유사시 자위대 개입 가능성 발언 이후 중국과 일본 관계가 악화 일로를- 5시간전
- 서울신문
-

유족·택배노조 “음주운전 안했는데 허위사실 유포… 쿠팡 상대 다음주 고소·고발”
지난달 10일 새벽배송 중 사고로 숨진 제주 쿠팡 배송기사 A(33)씨의 유가족과 택배노조가 쿠팡측의 허위사실 유포 및 사자- 5시간전
- 서울신문
-

산업부-Arm, 반도체·AI 협력 강화…인재 1400명 양성
산업통상부는 5일 휴머노이드 로봇 관련 반도체 시장에서 영향력이 커지고 있는 Arm과 ‘한국 반도체·인공지능(AI) 산업 강화- 5시간전
- 서울신문

